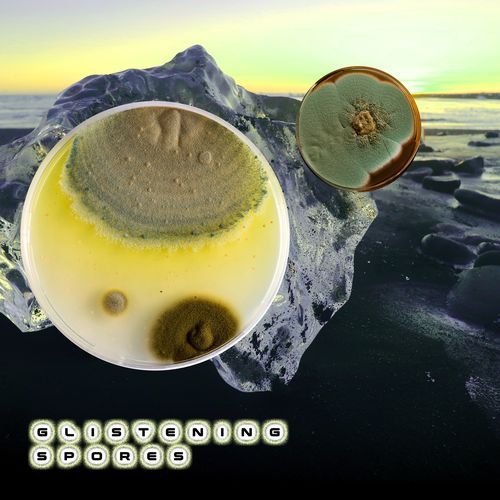

More from Glistening Spores
Loading
You Might Like
Loading
Currently Trending Songs
Loading
Top Songs By Same Artists
Loading
Top Songs By Same Actors
Loading
Artists
Singer
About Evening Lucid
Listen to Evening Lucid online. Evening Lucid is an Instrumental language song and is sung by Joe Mantis. Evening Lucid, from the album Glistening Spores, was released in the year 2026. The duration of the song is 1:36. Download Instrumental songs online from JioSaavn.
1m 36s · Instrumental